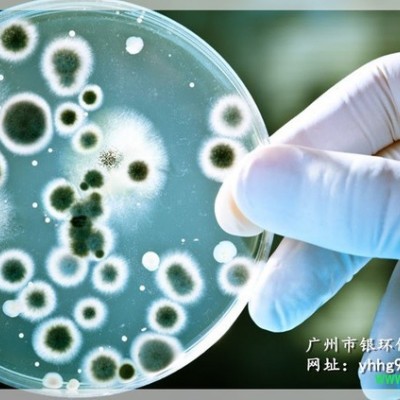

| 产地 | 广东 |
|---|---|
| 成分 | 甘油辛酸酯、辛酰羟肟酸、甘油月桂酸酯、1,2-辛二醇。 |
| 类型 | 通用 |
| 使用PH值范围 | 4.0-7.0 |
| 外观 | 无色透明 |
| 执行标准 | 国标 |
| 主要用途 | 非透明化妆品,膏霜,护肤品,护发品,日化通用。 |
| 有效物质含量 | 99(%) |
| 含量 | 99(%) |
| 品牌 | Y&H |
| 型号 | GC02 |
| 加工定制 | 否 |
产品概述GC-02
是新一代温和的无添加抑菌组合,其中甘油辛酸酯是人类母乳中的天然活性成分,能提高婴儿的疾病抵抗力和免疫力,可以应用于食品领域.甘油辛酸酯与其它组分的复配,形成了高增效的抗菌活性,同时具备温和,安全和"无添加"的优点.主要应用于非透明化妆品中。
防腐特性:
四种"无添加"活性物的独特组合,非常温和安全,能有效地控制多种细菌,真菌和酵母菌.不受原料中残留的还原剂影响.推荐用量与应用乳液,香波,护发素,湿巾等产品的防腐防霉,建议添加量为0.5-0.1%;青霜或含有较多天然成分产品的防腐防霉,建议添加量为1.0%;pH使用范围4~8;可在高温下加入,在低于50度加入更好。
化学组分
甘油辛酸酯、辛酰羟肟酸、甘油月桂酸酯、1,2-辛二醇。
物理特性
外观:无色透明液体(低温时不透明)
气味:无气味
溶解性:在使用浓度下易乳化在水中
有效期:24个月,低温储存易凝固,需要30℃以上的温度化解后使用,凝固不影响使用
GC-02**低抑菌浓度(Ml0,ppm)
细菌:金黄色葡萄球菌1500,大肠杆菌1000,绿脓杆菌15000;霉菌:黑曲霉1000,变色曲霉1250,宛氏拟青霉1200。
重要声明:本说明书是在我司多年经验基础上编制而成,仅供参考之用,请用户在使用我公司产品之前根据您的情况作好充分的试验和测试,并确认其结果是否符合您的特定要求。